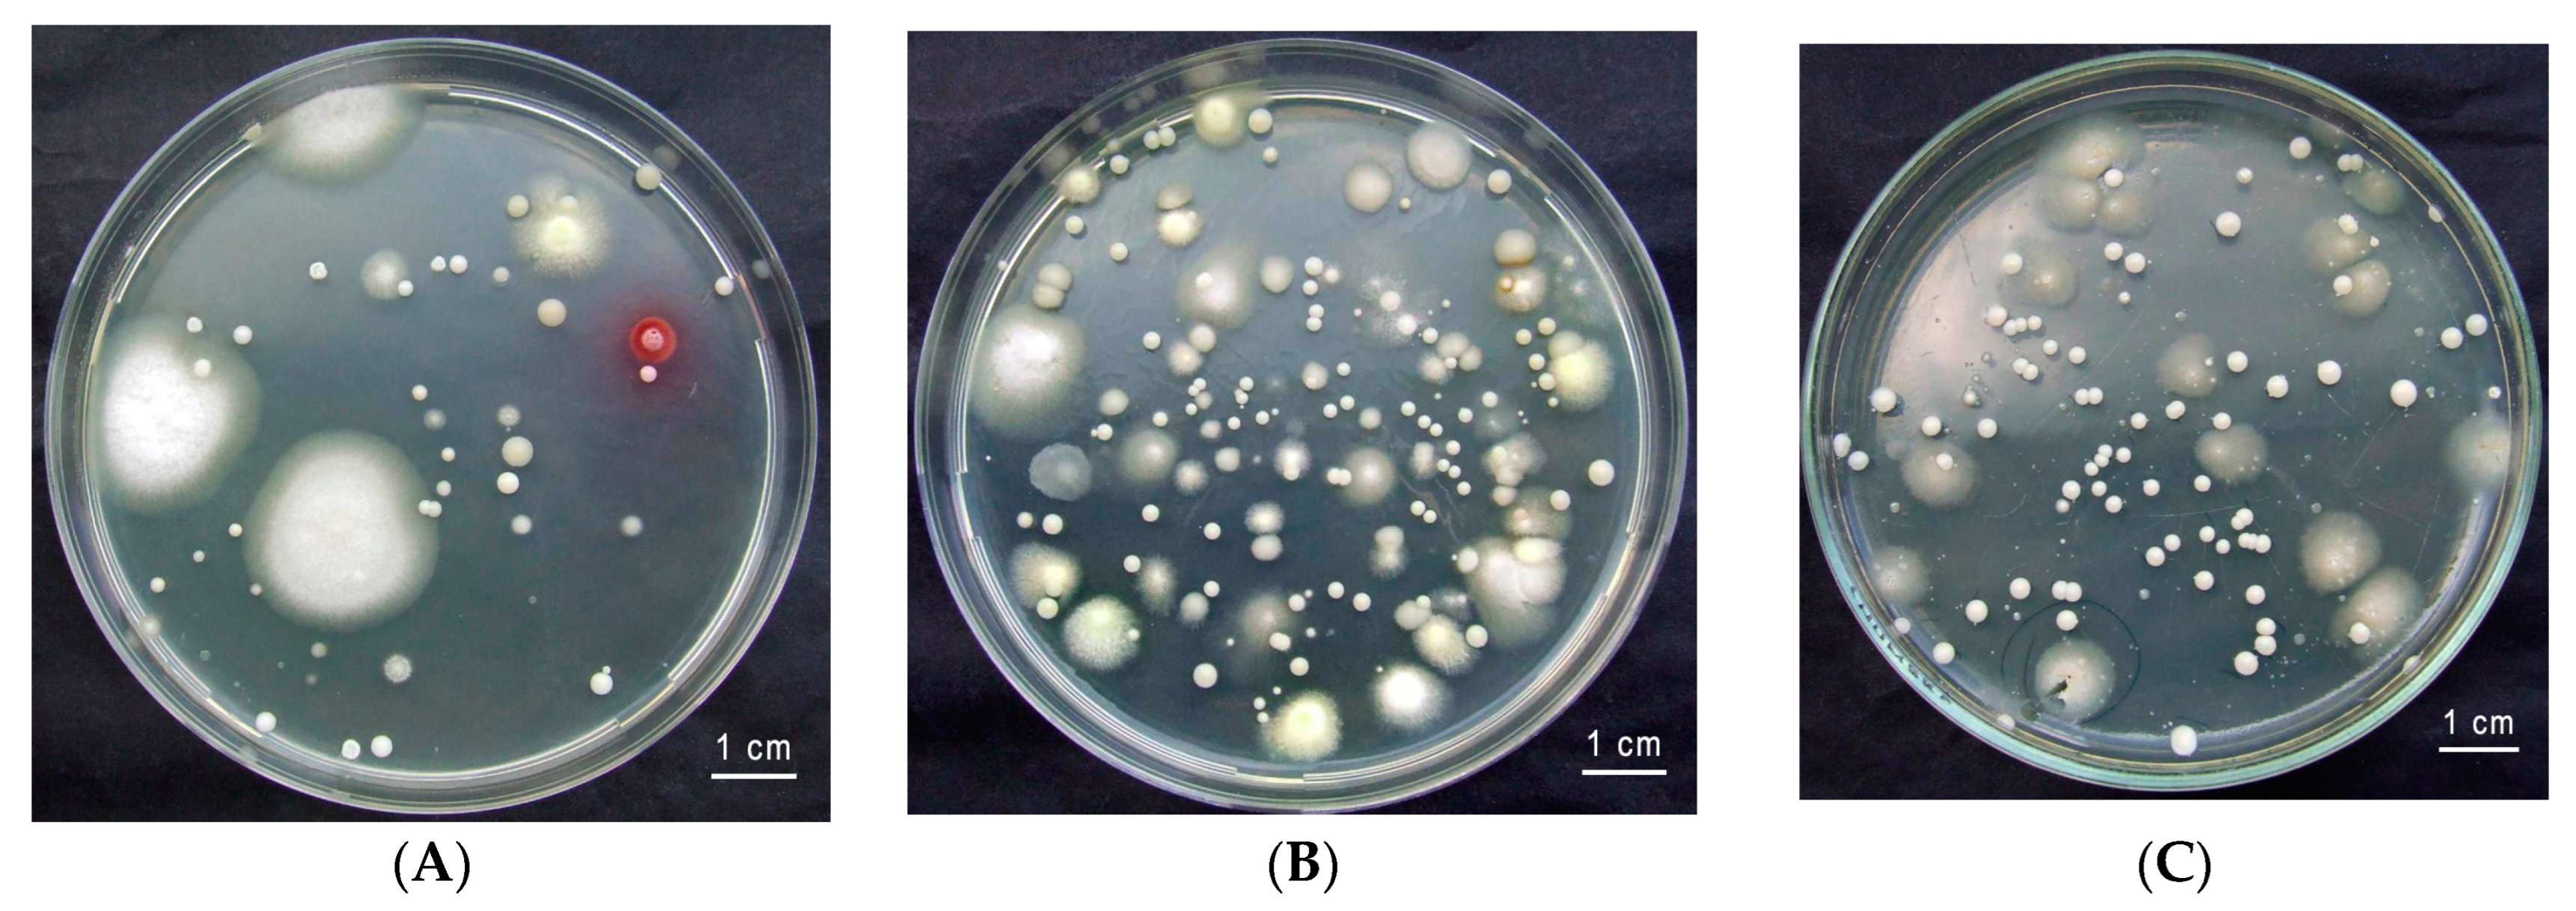
Jof 10 00442 g002 Jof 10 00442 g002

First Data on the Investigation of Gut Yeasts in Hermit Beetle (Osmoderma barnabita Motschulsky, 1845) Larvae in Lithuania
Abstract
1. Introduction
2. Material and Methods
2.1. Insect Collection and the Isolation of Yeasts
2.2. Phenotypic Characterization of Yeast
2.3. DNA Extraction PCR and Sequencing
2.4. Phylogenetic Analysis
3. Results
4. Discussion
5. Conclusions
Author Contributions
Funding
Institutional Review Board Statement
Informed Consent Statement
Data Availability Statement
Conflicts of Interest
References
- Tláskal, V.; Zrustová, P.; Vrška, T.; Baldrian, P. Bacteria associated with decomposing dead wood in a natural temperate forest. FEMS Microbiol. Ecol. 2017, 93, fix157. [Google Scholar] [CrossRef] [PubMed]
- Speight, M.C.D. Saproxylic invertebrates and their conservation. Nat. Environ. Ser. 1989, 42, 79–81. [Google Scholar]
- Fowles, A.P.; Alexander, K.N.A.; Key, R.S. The Saproxylic Quality Index: Evaluating wooded habitats for the conservation of dead-wood Coleoptera. Coleopterist 1999, 8, 121–141. [Google Scholar]
- Cavalli, R.; Mason, F. Techniques for Re-Establishment of Dead Wood for Saproxylic Fauna Conservation; LIFE Nature Project NAT/IT/99/6245 “Bosco della Fontana” (Mantova, Italy); Gianluigi Arcari Editore: Mantova, Italy, 2003. [Google Scholar]
- Speight, M.C.D.; Good, J.A. Development of eco-friendly forestry practices in Europe and the maintenance of saproxylic biodiversity. In Proceedings of the International Symposium “Dead Wood: A Key to Biodiversity”, Mantova, Italy, 29–31 May 2003; Mason, F., Nardi, G., Tisato, M., Eds.; Compagnia delle Foreste: Arezzo, Italy, 2003; Suppl. S2; pp. 73–77. [Google Scholar]
- Alexander, K.N.A. Tree biology and saproxylic Coleoptera: Issues of definitions and conservation language. Rev. d’Ecologie 2008, 10, 9–13. [Google Scholar] [CrossRef]
- Dodelin, B.; Gaudet, S.; Fantino, G. Spatial analysis of the habitat and distribution of Osmoderma eremita (Scop.) in trees outside of woodlands. Nat. Conserv. 2017, 19, 149–170. [Google Scholar] [CrossRef]
- Ratcliffe, B. Descriptions of the Larva and Pupa of Osmoderma subplanata (Casey) and Cremastocheilus wheeleri LeConte (Coleoptera: Scarabaeidae). J. Kans. Entomol. Soc. 1977, 50, 363–370. [Google Scholar]
- Baraud, J.; Tauzin, P. Une nouvelle espèce Europeenne du genre Osmoderma Serville. Lambillionea 1991, 91, 159–166. [Google Scholar]
- Sparacio, I. Osmoderma europee con descrizione di una specie dell’ italia meridionale. Nat. Sicil. 2000, XXIV, 225–239. [Google Scholar]
- Stegner, J.W. Der Eremit, Osmoderma eremita (Scopoli, 1763) (Coleoptera: Scarabaeidae), in Sachsen: Anforderungen an Schutzmaßnahmen für eine prioritäre Art der FFH-Richtlinie. [The Hermit-beetle Osmoderma eremita (Scopoli, 1763) (Coleoptera: Scarabaeidae) in Saxony: Required protective measures for a priority species in the sense of the habitats-directive]. Entomol. Nachrichten Berichte 2002, 46, 213–238. [Google Scholar]
- Bayartogtokh, B.; Kim, J.I.; Bae, Y.J. Lamellicorn beetles (Coleoptera: Scarabaeoidea) in Korea and Mongolia. Entomol. Res. 2012, 42, 211–218. [Google Scholar] [CrossRef]
- Webster, R.P.; Sweeney, J.D.; DeMerchant, I. New Coleoptera records from New Brunswick, Canada: Geotrupidae and Scarabaeidae. ZooKeys 2012, 179, 27–40. [Google Scholar] [CrossRef] [PubMed]
- Bezborodov, V.G. The genus Osmoderma (Coleoptera, Scarabaeidae, Trichiinae) in Siberia and the Russian Far East. Entomol. Rev. 2015, 95, 1088–1098. [Google Scholar] [CrossRef]
- Bezborodov, V.G. Lamellicorn Beetles (Coleoptera, Scarabaeoidea) of Manchuria (China): Fauna, Ecology, and Zoogeography. Entomol. Rev. 2018, 98, 528–551. [Google Scholar] [CrossRef]
- Ranius, T. Osmoderma eremita as an indicator of species richness of beetles in tree hollows. Biodivers. Conserv. 2002, 11, 931–941. [Google Scholar] [CrossRef]
- Audisio, P.; Brustel, H.; Carpaneto, G.M.; Coletti, G.; Mancini, E.; Piattella, E.; Trizzino, M.; Dutto, M.; Antonini, G.; De Biase, A. Updating the taxonomy and distribution of the European Osmoderma, and strategies for their conservation (Coleoptera, Scarabaeidae, Cetoniinae). Fragm. Entomol. 2007, 39, 273–290. [Google Scholar] [CrossRef]
- Alexander, K.N.A.; Buche, B.; Dodelin, B.; Schlaghamersky, J. Osmoderma barnabita. The IUCN Red List of Threatened Species 2010: e.T157901A5169119. Available online: https://doi.org/10.2305/IUCN.UK.2010-1.RLTS.T157901A5169119.en (accessed on 10 March 2024).
- Rašomavičius, V. (Ed.) Red Data Book of Lithuania. Animals, Plants, Fungi; Lututė: Kaunas, Lithuania, 2021; pp. 1–380. [Google Scholar]
- Ivinskis, P.; Davenis, S.A.; Rimšaitė, J. Status and distribution of Osmoderma barnabita Motschulsky, 1845 (Coleoptera) in Lithuania. In Proceedings of the 2nd International Conference “Smart Bio“, Kaunas, Lithuania, 3–5 May 2018; Abstract Book. p. 158. [Google Scholar]
- Hulcr, J.; Barnes, I.; De Beer, Z.W.; Duong, T.A.; Gazis, R.; Johnson, A.J.; Jusino, M.A.; Kasson, M.T.; Li, Y.; Lynch, S.; et al. Bark beetle mycobiome: Collaboratively defined research priorities on a widespread insect-fungus symbiosis. Symbiosis 2020, 81, 101–113. [Google Scholar] [CrossRef]
- Blackwell, M. Made for each other: Ascomycete yeasts and insects. In The Fungal Kingdom; Heitman, J., Howlett, B.J., Crous, P.W., Stukenbrock, E.H., Timothy, Y., James, T.Y., Gow, N.A.R., Eds.; American Society for Microbiology: Washington, DC, USA, 2017; pp. 945–962. [Google Scholar]
- Birkemoe, T.; Jacobsen, R.M.; Sverdrup-Thygeson, A.; Biedermann, P.H.W. Insect-Fungus Interactions in Dead Wood Systems. In Saproxylic Insects Diversity, Ecology and Conservation; Ulyshen, M.D., Ed.; Springer: Cham, Switzerland, 2018; pp. 377–427. [Google Scholar] [CrossRef]
- Chakraborty, A.; Modlinger, R.; Ashraf, M.Z.; Synek, J.; Schlyter, F.; Roy, A. Core Mycobiome and Their Ecological Relevance in the Gut of Five Ips Bark Beetles (Coleoptera: Curculionidae: Scolytinae). Front. Microbiol. 2020, 11, 568853. [Google Scholar] [CrossRef] [PubMed]
- Wang, Z.; Liu, Y.; Wang, H.; Meng, X.; Liu, X.; Zhang, X.; Lu, Q. Correction to: Ophiostomatoid fungi associated with Ips subelongatus, including eight new species from northeastern China. IMA Fungus 2020, 11, 8. [Google Scholar] [CrossRef]
- Gadanho, M.; Libkind, D.; Sampaio, J.P. Yeast diversity in the extreme acidic environments of the Iberian pyrite belt. Microb. Ecol. 2006, 52, 552–563. [Google Scholar] [CrossRef]
- Burgaud, G.; Arzur, D.; Durand, L.; Cambon-Bonavita, M.A.; Barbier, G. Marine culturable yeasts in deep-sea hydrothermal vents: Species richness and association with fauna. FEMS Microbiol. Ecol. 2010, 73, 121–133. [Google Scholar] [CrossRef]
- Cantrell, S.A.; Dianese, J.C.; Fell, J.; Gunde-Cimerman, N.; Zalar, P. Unusual fungal niches. Mycologia 2011, 103, 1161–1174. [Google Scholar] [CrossRef] [PubMed]
- Buzzini, P.; Branda, E.; Goretti, M.; Turchetti, B. Psychrophilic yeasts from worldwide glacial habitats: Diversity, adaptation strategies and biotechnological potential. FEMS Microbiol. Ecol. 2012, 82, 217–241. [Google Scholar] [CrossRef] [PubMed]
- Chung, D.; Kim, H.; Choi, H.S. Fungi in salterns. J. Microbiol. 2019, 57, 717–724. [Google Scholar] [CrossRef] [PubMed]
- Nagano, Y.; Miura, T.; Tsubouchi, T.; Lima, A.O.; Kawato, M.; Fujiwara, Y.; Fujikura, K. Cryptic fungal diversity revealed in deep-sea sediments associated with whale-fall chemosynthetic ecosystems. Mycology 2020, 11, 263–278. [Google Scholar] [CrossRef] [PubMed]
- Cadete, R.M.; Lopes, M.R.; Rosa, C.A. Yeasts Associated with Decomposing Plant Material and Rotting Wood. In Yeasts in Natural Ecosystems: Diversity; Buzzini, P., Lachance, M.A., Yurkov, A., Eds.; Springer: Cham, Switzerland, 2017; pp. 265–292. [Google Scholar] [CrossRef]
- Suh, S.; Blackwell, M. The beetle gut as a habitat for new species of yeasts. Insect–Fungal Associations. Ecol. Evol. 2005, 109 Pt 3, 244–256. [Google Scholar]
- Suh, S.O.; Marshall, C.J.; McHugh, J.V.; Blackwell, M. Wood ingestion by passalid beetles in the presence of xylose-fermenting gut yeasts. Mol. Ecol. 2003, 12, 3137–3145. [Google Scholar] [CrossRef] [PubMed]
- Kurtzman, C.P.; Fell, J.W.; Boekhout, T. The Yeasts, a Taxonomic Study, 5th ed.; Elsevier: San Diego, CA, USA, 2011; pp. 87–110. [Google Scholar]
- Frisvad, J.C. Media and growth conditions for induction of secondary metabolite production. Methods Mol. Biol. 2012, 944, 47–58. [Google Scholar] [CrossRef] [PubMed]
- Leaw, S.N.; Chang, H.C.; Sun, H.F.; Barton, R.; Bouchara, J.P.; Chang, T.C. Identification of medically important yeast species by sequence analysis of the internal transcribed spacer regions. J. Clin. Microbiol. 2006, 44, 693–699. [Google Scholar] [CrossRef] [PubMed]
- Boekhout, T.; Robert, V. Yeast in Food Beneficial and Detrimental Aspects; Behr’s Verlag: Hamburg, Germany, 2002; pp. 69–116. [Google Scholar]
- Stepień, Ł.; Gromeradzka, K.; Chełkowski, J.; Basińska-Barczak, A.; Lalak-Kończugowska, J. Diversity and mycotoxin production by Fusarium temperatum and Fusarium subglutinans as casual agents of pre-harvest Fusarium maize ear rot in Poland. J. Appl. Genet. 2019, 60, 113–121. [Google Scholar] [CrossRef]
- RStudio Team. RStudio: Integrated Development for R; RStudio, PBC: Boston, MA, USA, 2020; Available online: http://www.rstudio.com/ (accessed on 12 April 2024).
- Kolde, R. A Package for Drawing Pretty Heatmaps in R. Pheatmap: Pretty Heatmaps. 2013. Available online: https://github.com/raivokolde/pheatmap (accessed on 12 April 2024).
- Gao, C.-H.; Yu, G.; Cai, P. ggVennDiagram: An Intuitive, Easy-to-Use, and Highly Customizable R Package to Generate Venn Diagram. Front. Genet. 2021, 12, 706907. [Google Scholar] [CrossRef]
- Tamura, K.; Stecher, G.; Kumar, S. MEGA11: Molecular Evolutionary Genetics Analysis Version 11. Mol. Biol. Evol. 2021, 38, 3022–3027. [Google Scholar] [CrossRef] [PubMed]
- Tamura, K.; Nei, M. Estimation of the number of nucleotide substitutions in the control region of mitochondrial DNA in humans and chimpanzees. Mol. Biol. Evol. 1993, 10, 512–526. [Google Scholar] [PubMed]
- Kimura, M. A simple method for estimating evolutionary rates of base substitutions through comparative studies of nucleotide sequences. J. Mol. Evol. 1980, 16, 111–120. [Google Scholar] [CrossRef] [PubMed]
- Read, H. Veteran Trees: A Guide to Good Management; English Nature: Modern Arboriculture; Shigo and Tree Associates: Durham, NC, USA, 2000; pp. 11–24. [Google Scholar]
- Lonsdale, D. Principles of Tree Hazard Assessment and Management. Research for Amenity Trees No. 7; The Stationery Office: London, UK, 1999; p. 388. [Google Scholar]
- Skarpaas, O.; Blumentrath, S.; Evju, M.; Sverdrup-Thygeson, A. Prediction of biodiversity hotspots in the Anthropocene: The case of veteran oaks. Ecol. Evol. 2017, 7, 7987–7997. [Google Scholar] [CrossRef] [PubMed]
- Sverdrup-Thygeson, A.; Skarpaas, O.; Blumentrath, S.; Birkemoe, T.; Evju, M. Habitat connectivity affects specialist species richness more than generalists in veteran trees. For. Ecol. Manag. 2017, 403, 96–102. [Google Scholar] [CrossRef]
- Maurizi, E.; Campanaro, A.; Chiari, S.; Maura, M.; Mosconi, F.; Sabatelli, S.; Zauli, A.; Audisio, P.; Carpaneto, G.M. Guidelines for the monitoring of Osmoderma eremita and closely related species. Nat. Conserv. 2017, 20, 79–128. [Google Scholar] [CrossRef]
- Tsikas, A.; Karanikola, P. To Conserve or to Control? Endangered Saproxylic Beetles Considered as Forest Pests. Forests 2022, 13, 1929. [Google Scholar] [CrossRef]
- Garrick, R.C.; Reppel, D.K.; Morgan, J.T.; Burgess, S.; Hyseni, C.; Worthington, R.J.; Ulyshen, M.D. Trophic interactions among dead-wood-dependent forest arthropods in the southern Appalachian Mountains, USA. Food Webs 2019, 18, e00112. [Google Scholar] [CrossRef]
- Siitonen, J. Microhabitats. In Biodiversity in Dead Wood; Stokland, J., Siitonen, J., Jonsson, B.G., Eds.; Cambridge University Press: Cambridge, UK, 2012; pp. 150–182. [Google Scholar]
- Smolis, A.; Zając, K.; Tyszecka, K.; Kadej, M. Why is the hermit beetle so rare in Central European managed forests? Habitat requirements of the forest population of Osmoderma barnabita. For. Ecol. Manag. 2023, 548, 121407. [Google Scholar] [CrossRef]
- Ross, H.H.; Ross, C.A.; Ross, J.R.P. A Textbook of Entomology; Wiley: New York, NY, USA, 1982. [Google Scholar]
- Lopez-Guerrero, I. Anatomy and Histology of the Digestive System of Cephalodesmius armiger Westwood (Coleoptera, Scarabaeidae, Scarabaeinae). Coleopt. Bull. 2002, 56, 97–106. [Google Scholar] [CrossRef]
- Engel, P.; Moran, N.A. The gut microbiota of insects—Diversity in structure and function. FEMS Microbiol. Rev. 2013, 37, 699–735. [Google Scholar] [CrossRef]
- Stefanini, I. Yeast-insect associations: It takes guts. Yeast 2018, 35, 315–330. [Google Scholar] [CrossRef]
- Jönsson, N.; Méndez, M.; Ranius, T. Nutrient richness of wood mould in tree hollows with the Scarabaeid beetle Osmoderma eremita. Anim. Biodivers. Conserv. 2004, 27, 79–82. [Google Scholar]
- Davis, T.S. The Ecology of Yeasts in the Bark Beetle Holobiont: A Century of Research Revisited. Microb. Ecol. 2015, 69, 723–732. [Google Scholar] [CrossRef]
- Landvik, M.; Niemelä, P.; Roslin, T. Mother knows the best: An essential role for non-wood dietary components in the life cycle of a saproxylic scarab beetle. Oecologia 2016, 182, 163–176. [Google Scholar] [CrossRef] [PubMed]
- Malassigné, S.; Minard, G.; Vallon, L.; Martin, E.; Moro, C.V.; Luis, P. Diversity and Functions of Yeast Communities Associated with Insects. Microorganisms 2021, 9, 1552. [Google Scholar] [CrossRef] [PubMed]
- Yamamoto, D.; Toki, W. Presence of non-symbiotic yeasts in a symbiont-transferring organ of a stag beetle that lacks yeast symbionts found in other stag beetles. Sci. Rep. 2023, 13, 3726. [Google Scholar] [CrossRef] [PubMed]
- Hongoh, Y. Toward the functional analysis of uncultivable, symbiotic microorganisms in the termite gut. Cell. Mol. Life Sci. 2011, 68, 1311–1325. [Google Scholar] [CrossRef]
- Cook, D.M.; DeCrescenzo Henriksen, E.; Upchurch, R.; Peterson, J.B.D. Isolation of polymer-degrading bacteria and characterization of the hindgut bacterial community from the detritus-feeding larvae of Tipula abdominalis (Diptera: Tipulidae). Appl. Environ. Microbiol. 2007, 73, 5683–5686. [Google Scholar] [CrossRef]
- Andert, J.; Marten, A.; Brandl, R.; Brune, A. Inter- and intraspecific comparison of the bacterial assemblages in the hindgut of humivorous scarab beetle larvae (Pachnoda spp.). FEMS Microbiol. Ecol. 2010, 74, 439–449. [Google Scholar] [CrossRef]
- Huang, S.; Zhang, H. The impact of environmental heterogeneity and life stage on the hindgut microbiota of Holotrichia parallela larvae (Coleoptera: Scarabaeidae). PLoS ONE 2013, 8, e57169. [Google Scholar] [CrossRef] [PubMed]
- Egert, M.; Stingl, U.; Bruun, L.D.; Pommerenke, B.; Brune, A.; Friedrich, M.W. Structure and topology of microbial communities in the major gut compartments of Melolontha melolontha larvae (Coleoptera: Scarabaeidae). Appl. Environ. Microbiol. 2005, 71, 4556–4566. [Google Scholar] [CrossRef] [PubMed]
- Ravenscraft, A.; Berry, M.; Hammer, T.; Peay, K.; Boggs, C. Structure and function of the bacterial and fungal gut microbiota of Neotropical butterflies. Ecol. Monogr. 2019, 89, e01346. [Google Scholar] [CrossRef]
- Falqueto, S.A.; Rosa de Sousa, J.; Correla da Silva, R.; Ferreira da Silva, G.; Daniel Guariz Pinheiro, D.G.; Soares, M.A. Larval gut microbiome of Pelidnota luridipes (Coleoptera: Scarabaeidae): High bacterial diversity, different metabolic profiles on gut chambers and species with probiotic potential. World J. Microbiol. Biotechnol. 2022, 38, 210. [Google Scholar] [CrossRef] [PubMed]
- Klüber, P.; Müller, S.; Schmidt, J.; Zorn, H.; Rühl, M. Isolation of Bacterial and Fungal Microbiota Associated with Hermetia illucens Larvae Reveals Novel Insights into Entomopathogenicity. Microorganisms 2022, 10, 319. [Google Scholar] [CrossRef] [PubMed]
- Zhang, Z.; Jiao, S.; Li, X.; Li, M. Bacterial and fungal gut communities of Agrilus mali at diferent developmental stages and fed diferent diets. Sci. Rep. 2018, 8, 15634. [Google Scholar] [CrossRef] [PubMed]
- Mondal, S.; Somani, J.; Roy, S.; Babu, A.; Pandey, A.K. Insect Microbial Symbionts:Ecology, Interactions, and Biological Significance. Microorganisms 2023, 11, 2665. [Google Scholar] [CrossRef]
- Guo, Q.; Yao, Z.; Cai, Z.; Bai, S.; Zhang, H. Gut fungal community and its probiotic effect on Bactrocera dorsalis. Insects Sci. 2022, 29, 1145–1158. [Google Scholar] [CrossRef] [PubMed]
- Boekhout, T.; Amend, A.S.; Baidouri, F.E.; Gabaldón, T.; Geml, J.; Mittelbach, M.; Robert, V.; Tan, C.S.; Turchetti, B.; Vu, D.; et al. Trends in yeast diversity discovery. Fungal Divers. 2022, 114, 491–537. [Google Scholar] [CrossRef]
- Jacobsen, R.M.; Kauserud, H.; Sverdrup-Thygeson, A.; Bjorbækmo, M.M.; Birkemoe, T. Wood-inhabiting insects can function as targeted vectors for decomposer fungi. Fungal Ecol. 2017, 29, 76–84. [Google Scholar] [CrossRef]
- Hui, F.L.; Niu, Q.H.; Ke, T.; Liu, Z. Candida ficus sp. nov., a novel yeast species from the gut of Apriona germari larvae. Int. J. Syst. Evol. Microbiol. 2012, 62 Pt 11, 2805–2809. [Google Scholar] [CrossRef] [PubMed][Green Version]
- Hu, X.; Li, M.; Chen, H. Community structure of gut fungi during different developmental stages of the Chinese white pine beetle (Dendroctonus armandi). Sci. Rep. 2015, 5, 8411. [Google Scholar] [CrossRef] [PubMed]
- de Melo Pereira, G.V.; Maske, B.L.; de Carvalho Neto, D.P.; Karp, S.G.; De Dea Lindner, J.; Martin, J.G.P.; de Oliveira Hosken, B.; Soccol, C.R. What Is Candida Doing in My Food? A Review and Safety Alert on Its Use as Starter Cultures in Fermented Foods. Microorganisms 2022, 10, 1855. [Google Scholar] [CrossRef] [PubMed]
- Suh, S.O.; Nguyenn, N.H.; Blackwell, M. Nine new Candida species near C. membranifaciens isolated from insects. Mycol. Res. 2005, 109, 1045–1056. [Google Scholar] [CrossRef] [PubMed]
- Wang, S.A.; Li, F.L.; Bai, F.Y. Candida laoshanensis sp. nov. and Candida qingdaonensis sp. nov., anamorphic, ascomycetous yeast species isolated from decayed wood. Int. J. Syst. Evol. Microbiol. 2010, 60, 1697–1701. [Google Scholar] [CrossRef]
- Dlauchy, D.; Lee, C.F.; Péter, G. Spencermartinsiella ligniputridi sp. nov., a yeast species isolated from rotten wood. Int. J. Syst. Evol. Microbiol. 2012, 62, 2799–2804. [Google Scholar] [CrossRef] [PubMed]
- Nwaefuna, A.E.; Boekhout, T.; Aloy, M.G.; Vrhovsek, U.; Zhou, N. Diversity of dung beetle-associated yeasts from pristine environments of Botswana. Yeast 2023, 40, 182–196. [Google Scholar] [CrossRef]
- Rani, A.; Sharma, A.; Rajagopal, R.; Adak, T.; Bhatnagar, R.K. Bacterial diversity analysis of larvae and adult midgut microflora using culture-dependent and culture-independent methods in lab-reared and field-collected Anopheles stephensi-an Asian malarial vector. BMC Microbiol. 2009, 9, 96. [Google Scholar] [CrossRef]

| Sample | Site | Coordinates WGS84 | Host | Collection Date | Body Weight, g | Body Length, cm | Collector | |
|---|---|---|---|---|---|---|---|---|
| Longitude | Latitude | |||||||
| Larva 1 | Daudžgiriai Manor Park, Biržai district | 56.168662 | 24.650705 | Quercus robur | 10 July 2018 | 9.049 | 5.7 | Povilas Ivinskis |
| Larva 2 | Kaunas (Vytautas) Oak Park, Kaunas | 54.896247 | 23.931999 | Quercus robur | 31 July 2019 | 7.844 | 5.5 | Sigitas Algis Davenis |
Disclaimer/Publisher’s Note: The statements, opinions and data contained in all publications are solely those of the individual author(s) and contributor(s) and not of MDPI and/or the editor(s). MDPI and/or the editor(s) disclaim responsibility for any injury to people or property resulting from any ideas, methods, instructions or products referred to in the content. |
© 2024 by the authors. Licensee MDPI, Basel, Switzerland. This article is an open access article distributed under the terms and conditions of the Creative Commons Attribution (CC BY) license (https://creativecommons.org/licenses/by/4.0/).
Share and Cite
Švedienė, J.; Raudonienė, V.; Mizerienė, G.; Rimšaitė, J.; Davenis, S.A.; Ivinskis, P. First Data on the Investigation of Gut Yeasts in Hermit Beetle (Osmoderma barnabita Motschulsky, 1845) Larvae in Lithuania. J. Fungi 2024, 10, 442. https://doi.org/10.3390/jof10070442
Švedienė J, Raudonienė V, Mizerienė G, Rimšaitė J, Davenis SA, Ivinskis P. First Data on the Investigation of Gut Yeasts in Hermit Beetle (Osmoderma barnabita Motschulsky, 1845) Larvae in Lithuania. Journal of Fungi. 2024; 10(7):442. https://doi.org/10.3390/jof10070442
Chicago/Turabian StyleŠvedienė, Jurgita, Vita Raudonienė, Goda Mizerienė, Jolanta Rimšaitė, Sigitas Algis Davenis, and Povilas Ivinskis. 2024. "First Data on the Investigation of Gut Yeasts in Hermit Beetle (Osmoderma barnabita Motschulsky, 1845) Larvae in Lithuania" Journal of Fungi 10, no. 7: 442. https://doi.org/10.3390/jof10070442
APA StyleŠvedienė, J., Raudonienė, V., Mizerienė, G., Rimšaitė, J., Davenis, S. A., & Ivinskis, P. (2024). First Data on the Investigation of Gut Yeasts in Hermit Beetle (Osmoderma barnabita Motschulsky, 1845) Larvae in Lithuania. Journal of Fungi, 10(7), 442. https://doi.org/10.3390/jof10070442

